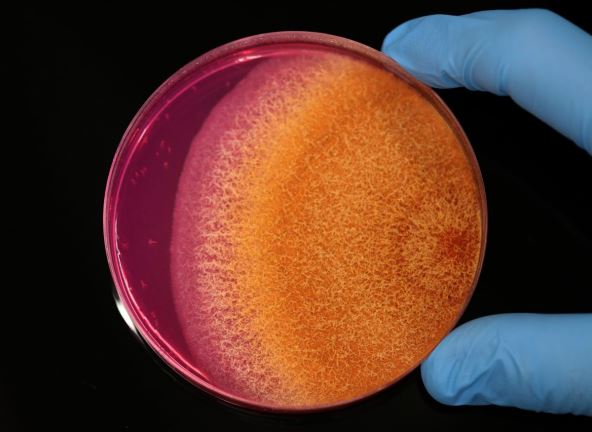

Smrtonosna gljivica mogla bi da se proširi na nova područja Evrope zbog porasta temperatura, pokazuje novo istraživanje o klimatskim promenama.
Aspergillus, vrsta plesni koja može da izazove plućne i disajne tegobe ako zarazi čoveka, godišnje bi mogla da zarazi milione ljudi dok se širi prema severnijim delovima Evrope, Azije i Amerike zbog rasta globalnih temperatura, navodi se u studiji.
Norman van Rijn, naučnik iz Wellcome Trusta i saradnik na Univerzitetu u Mančesteru koji je učestvovao u studiji, rekao je da se svet približava prelomnoj tački kada je reč o širenju gljivičnih patogena koji uspevaju u najrazličitijim sredinama, uključujući unutrašnjost kuća.
"Gljivične infekcije prouzrokovaće milione smrti širom sveta svake godine", rekao je Van Rijn.
Aspergiloza, bolest pluća uzrokovana sporama aspergillusa koje se mogu proširiti i na druge ljudske organe, jedan je od takvih oblika bolesti.
Van Rijn je za Financial Times izjavio: "Govorimo o stotinama hiljadama života i promenama u rasprostranjenosti vrsta na kontinentima. Za 50 godina sasvim će se promeniti ono što raste oko nas i od čega se ljudi razbolevaju".
"Devet miliona ljudi u Evropi bi bilo izloženo infekciji"
Aspergillus može da ima i korisna svojstva. Koristi se u industrijskoj i prehrambenoj proizvodnji, uključujući fermentaciju soja sosa i sakea. Udisanje njegovih spora ne izaziva bolest kod svih, ali ova gljivica može da bude posebno opasna za osobe koje boluju od astme i cistične fibroze ili imaju oslabljen imuni sistem.
Istraživanja gljivica pokazuju da bi aspergillus fumigatus do 2100. godine mogao da se proširi na dodatnih 77 posto teritorija zbog intenzivnog korišćenja fosilnih goriva, čime bi potencijalno devet miliona ljudi u Evropi bilo izloženo infekciji, piše FT.
Ova vrsta brzo raste pri visokim temperaturama u kompostu, što objašnjava zašto tako dobro uspeva na 37°C, koliko iznosi prosečna unutrašnja temperatura ljudskog tela.
"Njen način života u prirodnoj okolini možda je aspergillusu fumigatusu dao prednost potrebnu za kolonizaciju ljudskih pluća", rekla je profesorka Elejn Bignel, jedna od načelnika Centra za medicinsku mikologiju pri Univerzitetu u Ekseteru.
Druga vrsta, aspergillus flavus, živi na poljoprivrednim kulturama, a prema rečima istraživača, do 2100. godine mogla bi da se proširi na dodatnih 16 odsto teritorija u severnoj Kini, Rusiji, Skandinaviji i na Aljasci. Neka područja u afričkim zemljama i Brazilu mogla bi, pak, da postanu nepogodna za njen rast, što bi moglo da šteti lokalnim ekosistemima.
Profesor zaraznih bolesti i medicinske mikologije na Kraljevskom koledžu u Londonu Darijus Armstrong-Džejms rekao je za FT: "Ovaj organizam predstavlja ozbiljnu pretnju i za ljudsko zdravlje i za sigurnost snabdevanja hranom."
(EUpravo zato/FT.com)



